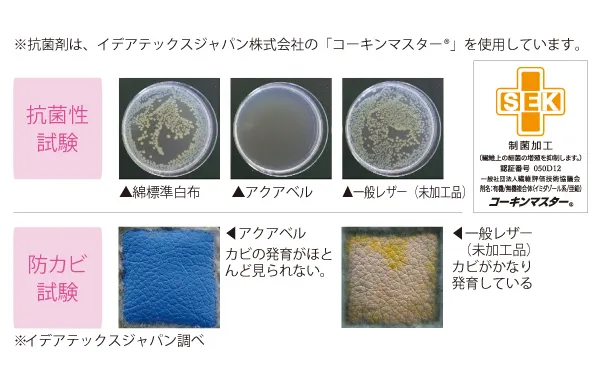
重錘バンド_制菌仕様_制菌テスト.webp

重錘バンド 制菌仕様追加のご案内
運動補助具 重錘バンドに制菌仕様が追加
重錘バンドは手首や足首に面ファスナーで簡単に装着できる運動補助具です。
トレーニング内容や目的に合わせて、11段階の重さを選べます。
今回新しく、「抗菌・防カビ機能を有するアクアベル」という繊維素材を使用した制菌仕様を追加しました。(2023年2月発売)
制菌仕様は一般社団法人繊維評価技術協議会の「SEKマーク」認証基準に適合し、制菌加工の認証番号を取得した素材を使用しています。細菌、カビの増殖を抑制するとともに、安全性と耐久性にも優れています。
商品一覧
|
商品番号
|
色(仕様)
|
重量(㎏)
|
サイズ(㎝)
|
価格(税込)
|
|
1096-00
|
オレンジ (標準仕様)
|
0.25
|
9.0×22.5
|
¥3,630
|
|
1096-01
|
青 (標準仕様)
|
0.5
|
9.5×27.5
|
¥4,400
|
|
1096-02
|
赤茶 (標準仕様)
|
0.75
|
9.5×30.5
|
¥4,950
|
|
1096-03
|
赤 (標準仕様)
|
1.0
|
11.0×34.0
|
¥5,500
|
|
1096-10
|
やまぶき (標準仕様)
|
1.5
|
12.5×34.5
|
¥6,380
|
|
1096-05
|
緑 (標準仕様)
|
2.0
|
18.0×36.0
|
¥7,370
|
|
1096-06
|
黄 (標準仕様)
|
2.5
|
18.5×40.0
|
¥8,250
|
|
1096-07
|
茶 (標準仕様)
|
3.0
|
20.0×40.5
|
¥8,800
|
|
1096-12
|
グレー (標準仕様)
|
4.0
|
21.5×45.0
|
¥12,100
|
|
1096-08
|
ベージュ (標準仕様)
|
5.0
|
23.0×50.0
|
¥13,200
|
|
1096-11
|
水色 (標準仕様)
|
7.5
|
26.0×54.5
|
¥16,940
|
|
1096-13
|
オレンジ (制菌仕様)
|
0.25
|
9.0×22.5
|
¥4,840
|
|
1096-14
|
青 (制菌仕様)
|
0.5
|
9.5×27.5
|
¥5,720
|
|
1096-15
|
赤茶 (制菌仕様)
|
0.75
|
9.5×30.5
|
¥6,380
|
|
1096-16
|
赤 (制菌仕様)
|
1.0
|
11.0×34.0
|
¥7,150
|
|
1096-17
|
やまぶき (制菌仕様)
|
1.5
|
12.5×34.5
|
¥8,360
|
|
1096-18
|
緑 (制菌仕様)
|
2.0
|
18.0×36.0
|
¥9,240
|
|
1096-19
|
黄 (制菌仕様)
|
2.5
|
18.5×40.0
|
¥10,230
|
|
1096-20
|
茶 (制菌仕様)
|
3.0
|
20.0×40.5
|
¥11,000
|
|
1096-21
|
グレー (制菌仕様)
|
4.0
|
21.5×45.0
|
¥14,850
|
|
1096-22
|
ベージュ (制菌仕様)
|
5.0
|
23.0×50.0
|
¥15,950
|
|
1096-23
|
重錘バンド(標準仕様) 全商品セット
|
¥70,400
|
||
|
1096-24
|
重錘バンド(標準仕様) 売れ筋商品セット
|
¥22,000
|
||
|
1096-25
|
重錘バンド(制菌仕様) 全商品セット
|
¥89,100
|
||
|
1096-26
|
重錘バンド(制菌仕様) 売れ筋商品セット
|
¥28,600
|
||
(注)全商品セット構成:0.25㎏~5.0㎏各種1個
(注)売れ筋商品セット構成:0.5㎏、1.0㎏、1.5㎏、2.0㎏各種1個
(注)販売時点の価格になります。
この記事の関連情報
*本⽂書に記載している情報は発表⽇時点のものです。
お問合せ
この記事のお問合せはこちらから。下のボタンを押すとお問合せフォームが開きます。




